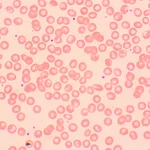
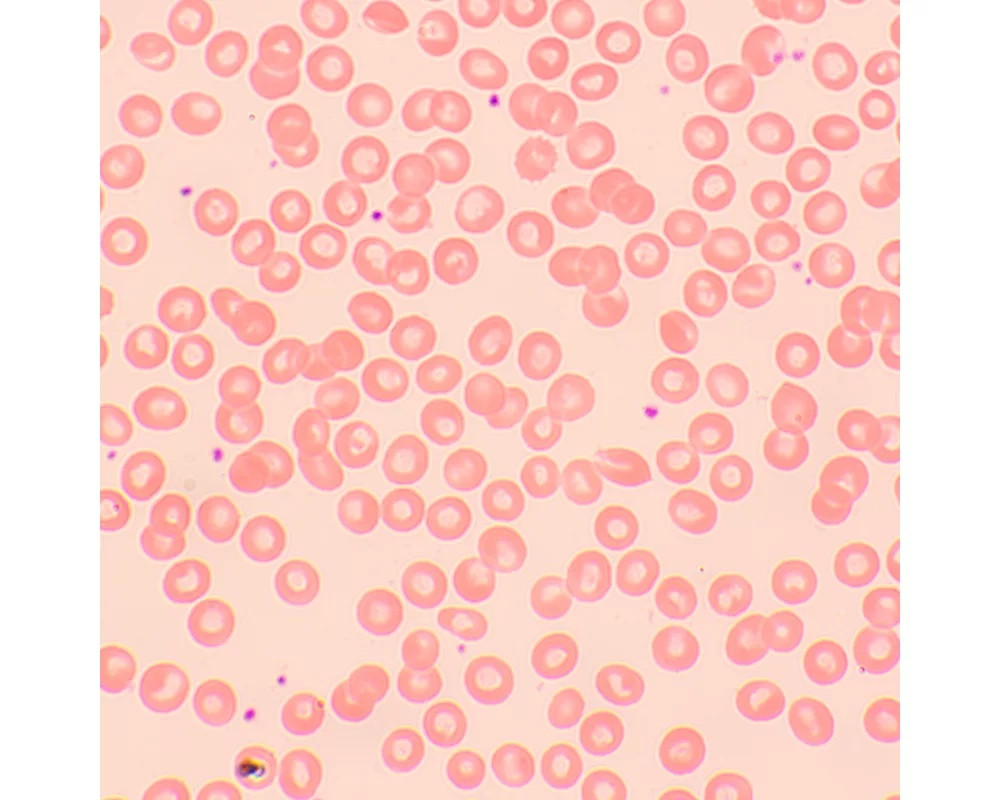
Микроскоп Биологичен цифров MAGUS Bio D250TL LCD 34

- Начало
- Оптични уреди и измервателни инструменти
- Микроскопи
- Magus
- Биологичен цифров MAGUS Bio D250TL LCD (ID: 693307)
Микроскоп Биологичен цифров MAGUS Bio D250TL LCD 83011
планахроматични обективи с корекция до безкрайност, светодиод 3 W
Гаранция:
0.0
от 5.0
(0)
Купи и събери
22 точки
Плати по-лесно и сигурно с
ID: 693307
Характеристики
| Тип | биологичен, светлина/оптичен, цифрови |
| Подходящо за | лабораторно/медицинско |
| Употреба | за професионалисти, опитни потребители |
| Монтаж и инсталиране | сложен |
| Technique | на светлото поле |
| Head | глава Gemel (Siedentopf, завъртане на 360°) |
| Head angle | 30 ° |
| Revolver | за 5 обектива |
| Увеличение, x | 40 — 1000 x |
| Окуляри | 10х/22 mm, разстояние от очите: 10 mm (*опция: 10x/22 mm със скала, 12,5x/14; 15x/15; 20x/12; 25x/9) |
| Диаметър на окуляра | 30 мм. |
| Диоптрична корекция на окуляра | ±5 (на лявата тръба) |
| Фокусиране | коаксиален, грубо фокусиране (21 mm, 39,8 mm/кръг, със застопоряващ бутон и бутон за регулиране на затягането) и фино фокусиране (0,002 mm) |
| Diaphragm | диафрагма с регулируема апертура, полева диафрагма с регулируем ирис |
| Objectives | планахроматични с корекция до безкрайност: 4x/0,10; 10x/0,25; 40xs/0,65; 100xs/1,25 (масло); парфокално разстояние: 45 mm (*опция: 20x/0,40; 60хs/0,80) |
| Филтри | да |
| Working distance | 21 (4x); 5 (10x); 0,66 (40xs); 0,36 (100xs); 8,8 (20x); 0,465 (60xs) mm |
| Разстояние между окулярите (IPD), mm | 48 — 75 мм. |
| Condenser |
кондензер Abbe
N.A. 1,25 с регулируем център регулируема височина диафрагма с регулируема апертура слот за плъзгач за метода на тъмното поле и плъзгач за фазовоконтрастно наблюдение монтировка тип „лястовича опашка“ |
| Light source type | светодиодно |
| Light source | светодиод 3 W |
| Light source placement | долно |
| Spectral range | 380–650 (вграден инфрачервен филтър) nm |
| Brightness control |
|
| Работна температура | -15 — 55 °С |
| Запис |
|
| Мегапиксели | 2 |
| Video format | *.h.264, *.mp4 |
| Image format | *.jpg |
| Pixel size | 2.9x2.9 μm |
| Expansion | USB мишка, фазовоконтрастно устройство (кондензер и обективи), кондензер за метода на тъмното поле в имерсионно масло (сух или в масло), устройства за поляризация (поляризатор и анализатор) |
| Camera power supply | променливотоков адаптер 12 V, 1 A |
| Camera operating temperature | -10 — 50 °С |
| Stage | 180x150 мм. |
| Stage adjustment | 75/50 |
| Stage features | двуосова механична предметна маса, без рейка за позициониране |
| Размери на продукта | 43x27x63 cm см. |
| Системни изисквания | не изисква връзка с компютър |
| Захранване |
220±22 V
50 Hz променливотокова мрежа променливотоково 110 V–220 V/постояннотоково 5–12 V 1 A (Тип-C) |
| Материал | плътен алуминий |
| Тегло | 12.65 kg кг. |
| Гаранция | 24 месеца |
| Код на продукта | 83011 |
Виж повече
Допълнителна информация
<p>Микроскопът MAGUS Bio D250TL LCD изследва тънки разрези и натривки на биологични образци. Наблюденията се извършват с преминаваща светлина по микроскопския метод на светлото поле. Светлинният източник е 3-ватов светодиод, а оптичните елементи включват планахроматични обективи с корекция до безкрайност. Микроскопът поддържа допълнителни принадлежности, включващи устройства за метода на тъмното поле, устройства за поляризация и фазов контраст. Този микроскоп е идеален избор за лабораторен анализ, изследвания и обучение.</p>
<p><strong>Цифрова камера</strong></p>
<p>MAGUS CHD10 е най-достъпната камера с интерфейс HDMI.<br />
Камерата е оборудвана с 2 MP сензор и създава реалистични Full HD изображения с разделителна способност 1920x1080 пиксела.<br />
Тя е автономна камера, която не изисква свързване с компютър или инсталиране на допълнителен софтуер. Камерата може да се свърже директно към телевизор, монитор или проектор, за да покаже изображение.
Интерфейсът HDMI осигурява висока и стабилна скорост на предаване на данните от камерата към външния екран. Видеозапис се заснема с 60 fps.<br />
Камерата комбинира висока честота на кадрите в секунда и широколентов HDMI. Поради това видеозаписите са ярки, няма „замръзвания“ или прекъсвания между кадрите. При максимална разделителна способност изображението е с добра детайлност, движещите се обекти се виждат без проблеми, а движението на обектите се показва без закъснения.</p>
<p><strong>Течнокристален монитор</strong></p>
<p>Мониторът MAGUS MCD20 е предназначен за използване на системата за визуализация на микроскопа MAGUS.<br />
Той е свързан към камера, която е монтирана на микроскопа за показване на изображения в реално време. Поддържа HDMI камери MAGUS с разделителна способност Full HD.<br />
Диагоналът на екрана е 13,3 инча. IPS матрицата осигурява ярки изображения при големи ъгли на видимост. Ако погледнете към дисплея под ъгъл, възпроизвеждането на цветовете не е нарушено.<br />
Дисплеят може да се постави на сгъваема стойка върху маса или шкаф, или да се монтира директно към камерата или към стойката на микроскопа.</p>
<p><strong>Оптика</strong></p>
<p>Тринокулярната глава включва две окулярни тръби за наблюдение и вертикална тръба за монтиране на цифрова камера (не е приложен). Тръбите са наклонени на 30° за удобно продължително наблюдение и могат да се завъртат на 360° съобразно височината на наблюдаващия. Има пръстен за регулиране на диоптъра, който се намира на лявата тръба.</p>
<p>Обективите са монтирани на револверна глава с 5 слота – четири обектива са монтирани, един слот е оставен за допълнителен обектив. В свободния слот може да бъде монтиран всякакъв допълнителен обектив за допълнително увеличение в диапазона на увеличение. Потребителят може да вижда обектива, поставен в оптичния път по време на наблюдението, понеже револверната глава е ориентирана навътре. Та запазва свободно пространството над предметната маса.</p>
<p>Диапазонът на увеличение е от 40x до 1000x (отнася се само за базовата конфигурация). При добавяне на допълнителни обективи горната граница на увеличението ще бъде увеличена.</p>
<p><strong>Осветление</strong></p>
<p>Монтираните в долната част на микроскопа светодиоди осигуряват ярко и равномерно осветление на обекта. При промяна на яркостта цветната температура не се променя. Мощността на осветлението е 3 W. То е със срок на експлоатация 50 000 часа. Осветителната система е с променливотоково захранване.</p>
<p>Осветлението на Кьолер може да се настройва чрез регулиране на позицията на кондензера на Abbe и отваряне и затваряне на диафрагмата на апертурата и полевата диафрагма. Можете за използвате плъзгач за метода на тъмното поле и плъзгач за фазовоконтрастно наблюдение (в кондензера има специален слот за тях). Чрез плъзгачите превключването между методите на изследване е много бързо.</p>
<p><strong>Предметна маса и механизъм за фокусиране</strong> </p>
<p>Предметната маса няма рейка за позициониране. Поради това тя няма да пречи при наблюденията и самият микроскоп ще заема по-малко място върху работния плот. Механичното приспособление, което мести образеца, може да се отстранява (полезно е при ръчно сканиране).</p>
<p>За регулиране на фокуса се използва грубо и фино фокусиране. Бутоните са разположени от двете страни. Тъй като са разположени по-близо до основата, не е необходимо да държите ръцете си вдигнати, докато работите. Можете да ги отпуснете върху масата. Грубото фокусиране има застопоряващ бутон и регулиране на затягането. Регулирането на фокуса е плавно и без усилия.</p>
<p><strong>Принадлежности</strong></p>
<p>Възможностите на микроскопа MAGUS Bio 250TL могат да бъдат разширени с помощта на гамата принадлежности, включително окуляри, обективи, плъзгачи за калибриране, цифрови камери, устройства за метода на тъмното поле, устройства за поляризация и фазов контраст.</p>
<p><strong>Основни характеристики на микроскопа:</strong> </p>
<ul>
<li>Тринокулярна глава, револверна глава за 5 обектива, коригираната до безкрайност планахроматична оптика </li>
<li>Окулярните тръби могат да се въртят на 360° за лесно регулиране съобразно височината на наблюдаващия</li>
<li>Има пръстен за регулиране на диоптъра на лявата тръба, грубо и фино регулиране на фокуса</li>
<li>Грубото фокусиране има застопоряващ бутон и регулиране на затягането</li>
<li>Кондензерът на Abbe може да се центрира, височината му може да се регулира, диафрагмата на апертурата и полевата диафрагма осигуряват възможност за настройка на осветлението на Кьолер</li>
<li>Източник на светлина за преминаваща светлина – светодиод 3 W с регулируема яркост, захранване 220 V</li>
<li>Опция за монтиране на допълнителни принадлежности</li>
</ul>
<p><strong>Основни характеристики на камерата:</strong></p>
<ul>
<li>Камерата работи автономно, без връзка с компютър или инсталиране на софтуер</li>
<li>Интерфейс HDMI за висока и стабилна скорост на предаване на данни</li>
<li>Разделителната способност на камерата е 1920x1080 pix – идеален избор за показване на изображения на Full HD монитор</li>
<li>60 fps за наблюдение на движещи се образци, заснемане на видеозаписи и преместване на образците без трептене или закъснения</li>
<li>Цветният CMOS сензор SONY Starvis с фоново осветление осигурява ниско ниво на шума и висока светлочувствителност дори при слаба осветеност. Ще получите по-чисти, по-ярки изображения с по-наситени цветове</li>
<li>Софтуер със заснемане на снимки и видеозаписи, редактиране, външен дисплей, линейни и ъглови измервания</li>
</ul>
<p><strong>Комплектът включва:</strong></p>
<ul>
<li>Цифрова камера MAGUS CHD10 (цифрова камера, HDMI кабел (1,5 m), USB мишка, 32 GB SD карта с памет, променливотоков захранващ адаптер 12 V/1 A (Евро), ръководство за потребителя и гаранционна карта)</li>
<li>Течнокристален монитор MAGUS MCD20</li>
<li>Основа с вход за захранване, светлинен източник за преминаваща светлина, механизъм за фокусиране, предметна маса, кондензер и револверна глава</li>
<li>Тринокулярна глава</li>
<li>Планахроматичен обектив с корекция до безкрайност: 4x/0,1</li>
<li>Планахроматичен обектив с корекция до безкрайност: 10x/0,25</li>
<li>Планахроматичен обектив с корекция до безкрайност: 40x/0,65 (пружинно натоварен)</li>
<li>Планахроматичен обектив с корекция до безкрайност: 100x/1,25 (пружинно натоварен)</li>
<li>Окуляри 10x/22 mm с голямо разстоянието от очите (2 бр.)</li>
<li>Чашки на окулярите (2 бр.)</li>
<li>Филтри (4 бр.)</li>
<li>Адаптер за камера с С-образна монтировка</li>
<li>Бутилка с имерсионно масло</li>
<li>Шестостенен ключ</li>
<li>Променливотоков захранващ кабел</li>
<li>Покривало против прах</li>
<li>Ръководство за потребителя и гаранционна карта</li>
</ul>
<p><strong>Предлагат се по заявка:</strong></p>
<ul>
<li>Окуляр 10x/22 mm със скала</li>
<li>Окуляр 12,5x/14 mm (2 бр.)</li>
<li>Окуляр 15x/15 mm (2 бр.)</li>
<li>Окуляр 20x/12 mm (2 бр.)</li>
<li>Окуляр 25x/9 mm (2 бр.)</li>
<li>Планахроматичен обектив с корекция до безкрайност: 20x/0,4</li>
<li>Планахроматичен обектив с корекция до безкрайност: 60x/0,80 (пружинно натоварен)</li>
<li>Фазовоконтрастно устройство</li>
<li>Плъзгач за фазовоконтрастно наблюдение</li>
<li>Кондензер за тъмно поле NA 0,9</li>
<li>Кондензер за метода на тъмното поле в имерсионно масло NA 1,36–1,25</li>
<li>Плъзгач за метода на тъмното поле</li>
<li>Устройство за поляризация</li>
<li>Плъзгач за калибриране</li>
</ul>
Виж повече
Допълнителна информация
Виж повече
Информация за производителя
| Контакт | [email protected] |
| Адрес | ул. Акад. Стефан Младенов 46, София, 1700, България |
| Уебсайт | https://magusmicro.bg/ |
Виж повече
Ние от PIC.bg постоянно полагаме усилия информацията на тази страница да е точна. В редки случаи съдържанието може да е некоректно. Всички снимки са с информативна цел и е възможно да съдържат аксесоари, които не са включени в стандартния пакет. Някои от спецификациите или цените могат да бъдат променяни от производителя без предизвестие или да съдържат експлоатационни грешки. Всички промоции, посочени в сайта, се предлагат до изчерпаване на количествата.
Отзиви
0.0
0 отзива.
5
0
4
0
3
0
2
0
1
0
Оцени продукта
Добави отзив